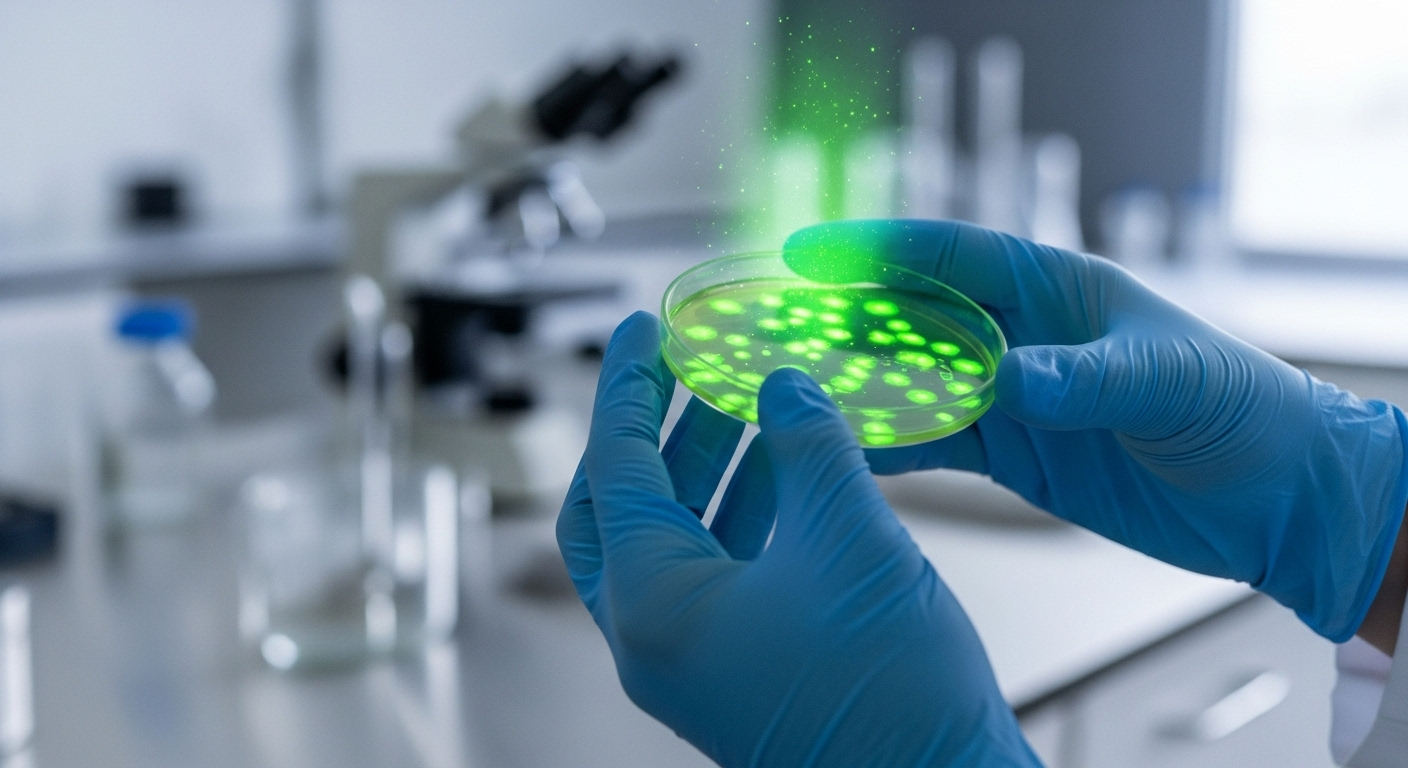
Et pour nous, les humains, c'est pour quand ?

Une lueur d’espoir contre Alzheimer : des cellules ‘jeunes’ pour rajeunir le cerveau ?
Auteur: Mathieu Gagnon
On a tous un proche, un ami, ou même soi-même, qui s’inquiète des pertes de mémoire en vieillissant. La maladie d’Alzheimer, c’est une peur qui nous touche de près. Mais une nouvelle récente venue des États-Unis pourrait bien changer la donne. Des chercheurs de l’institut Cedars-Sinai ont fait une découverte formidable sur des souris : ils ont réussi à inverser certains signes du vieillissement et d’Alzheimer dans leur cerveau. Comment ? Grâce à des cellules immunitaires toutes jeunes, fabriquées en laboratoire. C’est une piste très sérieuse, bien plus simple à imaginer pour nous, les humains, que les transfusions de sang jeune dont on a parfois entendu parler.
C'est quoi, au juste, ces cellules 'jeunes' ?

Imaginez des petites cellules dans votre corps qui agissent comme une équipe de nettoyage. Elles parcourent notre organisme pour se débarrasser de tout ce qui est mauvais ou endommagé. C’est le rôle des cellules immunitaires appelées ‘phagocytes mononucléés’. Le problème, c’est qu’avec l’âge, cette équipe de nettoyage devient moins efficace, un peu fatiguée. Elle laisse passer des choses, et c’est là que les soucis peuvent commencer, notamment dans notre cerveau.
L’idée des chercheurs était donc simple sur le papier : et si on remplaçait cette équipe fatiguée par une nouvelle, toute jeune et pleine d’énergie ?
La fabrique de cellules : un retour vers le futur

Pour créer ces nouvelles cellules, les scientifiques ont utilisé une technique qui ressemble un peu à de la science-fiction. Ils ont pris des cellules de peau d’adultes et les ont ‘reprogrammées’. C’est un peu comme s’ils avaient appuyé sur un bouton pour les faire revenir à leur état de jeunesse originel, quand elles n’étaient encore que des cellules souches. Des cellules capables de devenir n’importe quoi.
À partir de ces cellules souches ‘remises à zéro’, ils ont pu fabriquer en laboratoire une armée toute neuve de cellules nettoyeuses. Des cellules jeunes, performantes, prêtes à reprendre du service. C’est cette nouvelle équipe qu’ils ont ensuite injectée à des souris âgées et à d’autres qui avaient une maladie ressemblant à Alzheimer.
Des résultats vraiment bluffants chez les souris

Et alors là, surprise ! Les résultats ont dépassé les espérances. Les souris qui ont reçu ces cellules jeunes ont obtenu de bien meilleurs résultats aux tests de mémoire que les autres. C’est déjà énorme. Mais en regardant de plus près dans leur cerveau, les chercheurs ont vu d’autres changements très positifs.
Premièrement, elles avaient conservé beaucoup plus de ‘cellules moussues’, des cellules très importantes pour l’apprentissage et la mémoire qui se trouvent dans une zone du cerveau appelée l’hippocampe. Normalement, on en perd beaucoup avec l’âge et Alzheimer. Deuxièmement, les propres cellules immunitaires du cerveau des souris, les ‘microglies’, étaient en bien meilleure santé. Leurs petits bras, qui servent à détecter et nettoyer les débris, restaient longs et actifs, au lieu de rétrécir comme c’est le cas avec la maladie.
Le grand mystère : comment ça marche ?

Le plus fou dans tout ça, c’est que les chercheurs ne sont pas encore tout à fait sûrs de savoir *comment* ça a fonctionné. En fait, il semblerait que les nouvelles cellules jeunes ne soient même pas entrées dans le cerveau des souris. Alors, comment ont-elles pu avoir un effet aussi puissant ?
Les scientifiques ont deux théories principales. Soit les cellules ont libéré dans le sang des protéines bienfaitrices ou des toutes petites particules qui, elles, ont réussi à passer la barrière du cerveau pour le réparer. Soit elles ont agi comme un filtre dans le sang, en absorbant les mauvaises substances liées au vieillissement avant qu’elles n’atteignent le cerveau. Pour l’instant, c’est un mystère, et c’est ce sur quoi ils travaillent pour trouver le moyen le plus efficace d’en faire un traitement.
Et pour nous, les humains, c'est pour quand ?
C’est LA grande question. Pour l’instant, ce ne sont que des tests sur des souris, il faut rester prudent. Mais la voie est très prometteuse. L’avantage énorme de cette méthode, c’est qu’on pourrait créer ces cellules à partir de nos propres cellules. Ce serait donc un traitement personnalisé, sans risque de rejet. Et comme on peut les fabriquer en laboratoire, il n’y aurait pas de limite de quantité.
Le docteur Jeffrey A. Golden, un des responsables de l’étude, a dit que ces découvertes montrent qu’un traitement même court a amélioré la mémoire et la santé du cerveau. C’est donc un candidat très sérieux pour de futurs essais cliniques sur des patients. On n’y est pas encore, mais la recherche avance à grands pas.
Conclusion : Un espoir bien réel

Il ne faut pas vendre la peau de l’ours avant de l’avoir tué, comme on dit. Mais cette découverte est plus qu’un simple petit pas. C’est une nouvelle approche, une nouvelle façon de voir le problème, qui pourrait un jour nous aider à combattre les effets du temps sur ce que nous avons de plus précieux : nos souvenirs et notre esprit. C’est une belle raison de garder espoir et de suivre avec attention les prochaines avancées de ces chercheurs.
Selon la source : scitechdaily.com










